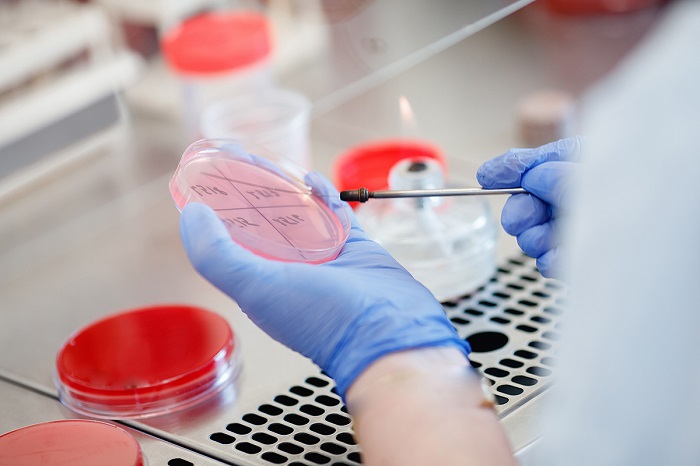
آزمایش‌های تشخیص سوزاک

سوزاک یکی از بیماریهای مقاربتی یا STD است که به علت باکتریهای نایسریا گونوره ایجاد میشود. باکتری Gonorrhoeae قسمتهایی را تحت هدف قرار میدهد که دارای غشای مخاطی هستند؛ مثل دهانه رحم، لولههای فالوپ و آلت تناسلی و همچنین ممکن است به مجاری ادراری هم سرایت کنند.
متاسفانه سوزاک در زنان و مردان ممکن است علائم خاصی مثل سوزش، درد یا حتی خارش نداشته باشد و همچنان به آن مبتلا باشد. بهترین راه، پیشگیری و درمان زود هنگام است و میبایست هر چند ماه یکبار آزمایش چکاپ داده و از سلامت جنسی خود مطمئن شوید.
در ادامه با تهران لب همراه باشید تا اطلاعات کامل و تکمیلی درباره بیماری سوزاک در اختیارتان قرار دهیم.
سوزاک چیست؟
سوزاک، که در انگلیسی به آن gonorrhea میگویند، یکی از بیماریهای شایع مقاربتی است که هم مردان و هم زنان را تحت تأثیر قرار میدهد. با این حال، شیوع آن در مردان بیشتر است. عامل ایجادکننده این بیماری، باکتری نایسریا گونوره است که تمایل به آلوده کردن بخشهای گرم و مرطوب بدن دارد، از جمله:
- مجرای ادراری
- چشمها
- گلو
- واژن
- آلت تناسلی مردانه
- مقعد
- دستگاه تناسلی زنان
در صورتی که سوزاک به موقع تشخیص داده شود، به راحتی قابل درمان است. اما اگر درمان نشود، میتواند منجر به عوارض طولانی مدت و جدی شود. اگر علائمی مشابه موارد ذکر شده دارید، توصیه میشود هرچه سریعتر به پزشک متخصص عفونی مراجعه کنید.
چرا به سوزاک مبتلا میشویم و چگونه این بیماری انتقال مییابد؟
سوزاک یک بیماری مقاربتی است که توسط باکتری نایسریا گونوره از طریق تماس جنسی منتقل میشود. لازم به ذکر است که در مردان، برای انتقال این بیماری، نیازی به انزال نیست و این باکتری میتواند در هر مرحله از رابطه جنسی انتقال یابد. بیشتر موارد انتقال از طریق روابط جنسی محافظت نشده اتفاق میافتد.
این بیماری بسیار مسری است و به راحتی از طریق تماس جنسی گسترش مییابد. مشابه سایر عفونتهای باکتریایی، نایسریا گونوره نیز میتواند از طریق تماس مستقیم با ناحیه آلوده بدن فرد مبتلا انتقال یابد.
اما برخلاف برخی عوامل عفونی دیگر، این باکتری خارج از بدن توانایی زنده ماندن را ندارد؛ بنابراین، احتمال انتقال آن از طریق لمس اشیا یا لباسها بسیار کم است.
سوزاک از طریق رابطه جنسی دهانی، مقعدی یا واژنی بدون استفاده از کاندوم یا دیگر روشهای حفاظتی از فرد مبتلا به فرد دیگر منتقل میشود.
همچنین، نوزادانی که از مادران مبتلا به سوزاک به دنیا میآیند، ممکن است به این عفونت مبتلا شوند که این بیماری معمولاً در نوزادان، چشمها را تحت تأثیر قرار میدهد.
هر فردی که از لحاظ جنسی فعال است، در معرض خطر ابتلا به این بیماری قرار دارد، به ویژه در میان افراد جوان. سایر عوامل خطر شامل موارد زیر هستند:
- برقراری رابطه جنسی با فردی جدید
- داشتن رابطه جنسی با فردی که با افراد دیگر نیز رابطه دارد
- داشتن چندین شریک جنسی
- سابقه ابتلا به سوزاک
- سابقه ابتلا به دیگر بیماریهای مقاربتی
انواع سوزاک کدامند؟
انواع سوزاک بر اساس محل درگیری در بدن به سه دسته تقسیم میشود: عفونت ادراری-تناسلی، عفونتهای خارج تناسلی و عفونتهای گنوکوکی.
در ادامه به بررسی برخی از این انواع و علائم مربوط به آنها میپردازیم:
- سوزاک مقعدی (مخرج): این نوع عفونت با علائمی مانند خارش مقعد، ترشحات چرکی و مشاهده لکههای خون روشن روی دستمال توالت همراه است.
- سوزاک چشمی: عفونت چشمها میتواند به سوزاک خفیف، درد و سوزش چشمها، حساسیت به نور و ترشحات چرکی از یک یا هر دو چشم منجر شود.
- سوزاک حلق و دهان: این نوع از سوزاک ممکن است باعث درد گلو و تورم غدد لنفاوی گردن شود. درمان این عفونت معمولاً با آنتیبیوتیک و شربتهای ضدعفونی کننده گلو صورت میگیرد.
- سوزاک مفصلی: اگر یک یا چند مفصل توسط باکتری آلوده شوند، این مفاصل ممکن است متورم، قرمز، گرم و دردناک شوند، به خصوص هنگام حرکت.
- سوزاک تناسلی: افرادی که از لحاظ جنسی فعال هستند، ممکن است به سوزاک تناسلی مبتلا شوند. علائمی مانند سوزش هنگام ادرار، زخمهای غیرمعمول یا بثورات پوستی ممکن است نشانه ابتلا به این نوع عفونت باشند. در صورت بروز این علائم، توصیه میشود که رابطه جنسی را متوقف کرده و فوراً به پزشک مراجعه کنید.
- سوزاک واژن: علائمی مانند درد یا حساسیت در ناحیه پایین شکم، خونریزی بین دورههای قاعدگی، پریودهای شدیدتر از حالت طبیعی و خونریزی بعد از رابطه جنسی از نشانههای سوزاک واژن هستند.
علائم سوزاک شامل چیست؟
از آنجایی که بسیاری از مبتلایان به سوزاک فاقد علائم خاصی هستند، اکثراً نمیدانند که چه زمانی به سوزاک مبتلا شدهاند. برخی اوقات، علائم سوزاک ظرف ۲ تا ۱۴ روز بعد از ابتلا به ویروس خودشان را نشان میدهند. اما فراموش نکنید که فردی که هیچ علائمی ندارد هم میتواند این بیماری را منتقل کند.

علائم سوزاک در کودکان و نوجوانان
در برخی از کودکان و نوجوانان، به دلیل نفوذ باکتری نایسریا گونوره، ممکن است علائم زیر مشاهده شود:
- خونریزی از ناحیه تناسلی یا راست روده
- سوزش هنگام ادرار
- قاعدگی نامنظم
- درد در ناحیه تحتانی شکم که معمولاً دختران و زنان را تحت تأثیر قرار میدهد
- درد در ناحیه رکتوم
علائم سوزاک در مردان
سوزاک در مردان ممکن است تا چند هفته بدون علامت باشد. معمولاً علائم این بیماری حدود یک هفته پس از انتقال ظاهر میشوند. نخستین علامت قابل توجه در مردان، سوزش و درد هنگام ادرار است.
در برخی موارد نادر، سوزاک پیشرفت کرده و منجر به آسیب در مجاری ادراری و بیضهها میشود. استفاده از قرصهای مخصوص برای درمان سوزاک ادراری توصیه میشود. با ادامه یافتن عفونت، علائم دیگری نیز بروز پیدا میکنند، از جمله:
- تکرر ادرار همراه با درد به علت سوزش
- ترشحات چرکی از آلت تناسلی به رنگهای سفید، زرد یا سبز مایل به سبز
- ورم یا قرمزی در دهانه مجرای آلت
- تورم یا درد بیضهها
- گلودرد مداوم
علائم سوزاک در زنان
سوزاک در زنان معمولاً علائم آشکاری ندارد. در صورت بروز علائم، این نشانهها خفیف و مشابه سایر عفونتها مانند عفونت قارچی یا باکتریایی هستند که تشخیص را دشوارتر میکند. از علائمی که ممکن است به دلیل سوزاک در زنان ظاهر شوند، میتوان به موارد زیر اشاره کرد:
- افزایش ترشحات واژن به رنگهای آبکی، کرم رنگ یا متمایل به سبز
- درد و سوزش هنگام ادرار
- تکرر ادرار
- قاعدگی سنگین یا دردناک یا لکه بینی بعد از رابطه جنسی
- گلودرد
- درد هنگام رابطه جنسی
- درد شدید در ناحیه پایینی شکم یا لگن
- گسترش عفونت به دلیل خارش در ناحیه واژن
علائم عفونت سوزاک در حاملگی
سوزاک در دوران بارداری میتواند عارضهای جدی و ناراحت کننده برای زنان باردار باشد. در صورت مشاهده علائم، لازم است که سریعاً به پزشک متخصص زنان مراجعه کنید تا عفونت کنترل و درمان شود. از علائم رایج سوزاک در بارداری میتوان به موارد زیر اشاره کرد:
- ادرار دردناک همراه با سوزش
- ترشحات واژنی سفید یا زرد با ظاهر غیرعادی
- درد لگن یا شکم تحتانی
- درد در هنگام مقاربت
آزمایشهای تشخیص سوزاک
برای تشخیص قطعی بیماری سوزاک، پزشک از نمونهای از ترشحات دستگاه تناسلی، گلو یا مقعد آزمایش کشت یا آزمایش DNA انجام میدهد. این آزمایشها به شناسایی باکتری نایسریا گونوره، عامل ایجاد کننده سوزاک، کمک میکنند.
انواع آزمایشهای تشخیص سوزاک
- آزمایش میکروبیولوژی: در این آزمایش، نمونهای از ترشحات روی یک محیط کشت قرار میگیرد تا باکتریها رشد کنند.
- آزمایش ژنتیک: این آزمایش به تشخیص سریعتر باکتری کمک میکند و به طور معمول در آزمایشگاه انجام میشود. این آزمایش از تکنیک PCR استفاده میکند که به تکثیر DNA باکتری اجازه میدهد و تشخیص آن را آسانتر میکند.
- آزمایش ادرار: در برخی موارد، پزشک ممکن است از آزمایش ادرار برای تشخیص سوزاک استفاده کند. این آزمایش معمولاً برای مردان مناسبتر است.
عوارض سوزاک
سوزاک در صورتی که به موقع و زودهنگام شناسایی شود شانس درمان بالایی دارد، در غیر این صورت میتواند به خصوص در خانمها عوارض بلند مدتی داشته باشد و آسیبهایی وارد کند که در خانمها شدیدتر هستند. ناباروری و نازایی یکی از این عوارض هستند.
۱. نازایی در زنان
سوزاک میتواند به رحم و لولههای فالوپ گسترش یافته و منجر به بیماری التهابی لگن (PID) شود. این عارضه باعث ایجاد زخم در لولههای فالوپ میشود و احتمال ناباروری در زنان را افزایش میدهد. بیماری التهابی لگن به درمان فوری نیاز دارد. در صورتی که لولههای فالوپ به دلیل سوزاک مسدود شوند، احتمال بارداری خارج از رحم افزایش مییابد که این امر نه تنها به از دست رفتن جنین منجر میشود، بلکه زندگی مادر را نیز به خطر میاندازد.
۲. نازایی در مردان
سوزاک ممکن است مجرای اپیدیدیم، که اسپرمها را از بیضهها انتقال میدهد، را دچار التهاب کند. در صورت عدم درمان، التهاب اپیدیدیم میتواند به ناباروری در مردان منجر شود.
۳. گسترش عفونت به مفاصل و سایر نقاط بدن
باکتری نایسریا گونوره میتواند از طریق جریان خون به نقاط دیگر بدن گسترش یابد. این حالت ممکن است علائمی مانند تب، جوش، زخمهای پوستی، درد و ورم مفاصل ایجاد کند. در این شرایط، توصیه میشود که از فوق تخصص اورولوژی کمک بگیرید تا عوارض بیماری به حداقل برسد.
۴. افزایش احتمال ابتلا به HIV
افرادی که به سوزاک مبتلا هستند، بیشتر در معرض ابتلا به ویروس HIV، عامل بیماری ایدز، قرار دارند. همچنین، کسانی که به طور همزمان سوزاک و ایدز دارند، میتوانند به سرعت هر دو بیماری را به شریک جنسی خود منتقل کنند.
۵. عوارض در نوزادان
نوزادانی که از مادران مبتلا به سوزاک متولد میشوند، ممکن است با مشکلاتی مانند کوری، زخمهای پوست سر و عفونتهای شدید مواجه شوند. این عوارض نیازمند مداخله سریع پزشکی هستند تا از آسیبهای جدیتر جلوگیری شود.
درمان سوزاک چگونه است؟
درمان سوزاک با استفاده از آنتیبیوتیکهای مدرن بسیار مؤثر است. بسیاری از مراکز بهداشتی، به ویژه کلینیکهای تحت حمایت ایالتی، خدمات رایگان تشخیص و درمان سوزاک را ارائه میدهند.
- روشهای درمان خانگی: هیچ روش خانگی یا درمان بدون نسخه برای سوزاک وجود ندارد. در صورت مشکوک شدن به این بیماری، لازم است به یک متخصص عفونی مراجعه کنید.
- آنتیبیوتیکهای مؤثر در درمان سوزاک: سوزاک معمولاً با یک بار تزریق سفتریاکسون به عضله سرینی یا یک دوز از قرص آزیترومایسین درمان میشود. پس از مصرف آنتیبیوتیک، علائم بیماری معمولاً ظرف چند روز برطرف میشوند.
- اهمیت درمان همزمان شرکای جنسی: برای جلوگیری از انتقال مجدد بیماری، تمام افرادی که با فرد مبتلا به سوزاک رابطه جنسی داشتهاند، باید همزمان تحت درمان قرار گیرند.
سوزاک یکی از بیماریهای مقاربتی است که ممکن است علائم خاصی از خود نداشته باشد. با این حال، در صورت عدم تشخیص و ابتلا به عوارض بلند مدت، این بیماری میتواند آسیبهایی از جمله نازایی را به همراه داشته باشد. شما عزیزان میتوانید پس از مراجعه به پزشک و تجویز آزمایش، برای تمامی آزمایشهای سوزاک به تهران لب مراجعه کنید.
منبع:













